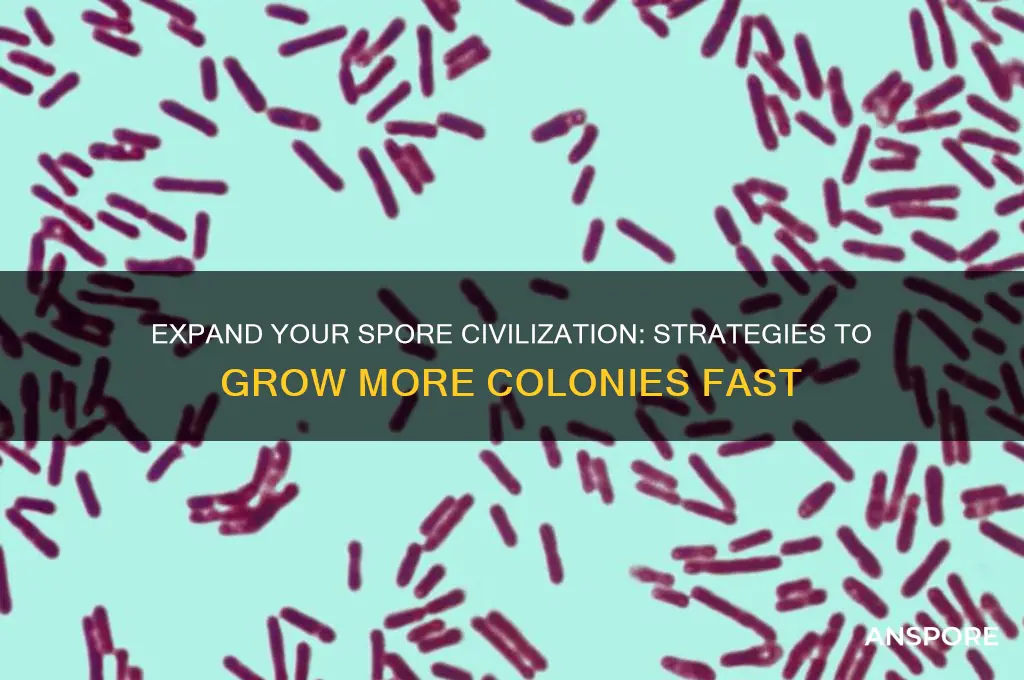
how do you get more collonies in spore

In *Spore*, expanding your civilization and acquiring more colonies is a key aspect of progressing through the game, particularly in the Space Stage. To get more colonies, players must first explore the galaxy to discover habitable planets, which are indicated by a green icon. Once a suitable planet is found, you’ll need to either negotiate with or conquer the existing inhabitants, depending on your chosen playstyle. Negotiations require offering resources or establishing trade routes, while conquest involves deploying your spacecraft and creatures to defeat the planet’s defenders. Additionally, upgrading your spacecraft with better weapons, shields, and terraforming tools can make colonization easier. Managing your empire’s resources, such as spices and energy, is also crucial, as these are often needed to sustain and expand your colonies. By balancing exploration, diplomacy or aggression, and resource management, players can steadily grow their interstellar empire in *Spore*.
| Characteristics | Values |
|---|---|
| Game Mode | Civilization Stage |
| Primary Requirement | Reach and settle on other planets |
| Sporepods | Use Sporepods to transport your creatures to new planets |
| Colony Requirements | - Clear out predators - Build a colony structure - Attract settlers |
| Settler Attraction | Provide food, entertainment, and housing |
| Colony Growth | Increase population by meeting settlers' needs |
| Interplanetary Travel | Unlock and use spaceships for faster travel |
| Planet Types | T-0 (Earth-like) planets are ideal for colonization |
| Resource Management | Gather spices and other resources to sustain colonies |
| Diplomacy | Ally with or conquer other empires to expand influence |
| Technology | Research and unlock advancements to aid colonization |
| Challenges | Defend colonies from rival creatures or empires |
| Max Colonies | Limited by the number of habitable planets in the galaxy |
| Game Progression | Colonization is a key step toward the Space Stage |
| Tips | - Focus on T-0 planets - Prioritize resource-rich locations - Use allies strategically |
Explore related products
$17.55 $30.99
What You'll Learn
- Maximize Spore Flowers: Plant spore flowers near colonies to attract more spores and increase colony growth
- Upgrade Colony Plots: Use resources to upgrade colony plots, increasing their capacity for more spores
- Complete Quests: Finish quests to unlock rewards that boost colony expansion and spore attraction
- Strategic Placement: Place colonies near high-spore areas like gardens or spore-rich environments for faster growth
- Use Spore Boosts: Activate spore boosts or power-ups to accelerate colony development and attract more spores

Maximize Spore Flowers: Plant spore flowers near colonies to attract more spores and increase colony growth
Spore flowers are not just decorative elements in the Spore universe; they are strategic tools for colony expansion. By planting these flowers near existing colonies, you can create a magnetic effect, drawing in more spores and accelerating growth. This method leverages the game’s mechanics, where spores are naturally attracted to areas with high floral density. Think of spore flowers as beacons, signaling to passing spores that a thriving colony is nearby and ready to expand.
To maximize their effectiveness, plant spore flowers in clusters rather than scattering them individually. A group of 3–5 flowers within a 10-unit radius of a colony creates an optimal attraction zone. Ensure the flowers are placed on flat, fertile terrain, as uneven or rocky ground can hinder spore movement. Additionally, avoid overcrowding the area with other structures, as this can disrupt the spores’ pathfinding. Regularly monitor the flowers’ health, as withered or dying plants lose their allure and may even repel spores.
While spore flowers are powerful, they are not a standalone solution. Combine their use with other colony-boosting strategies for best results. For example, pair flower clusters with spore-friendly terrain modifications, such as smoothed paths or cleared obstacles, to guide spores directly to the colony. Also, consider planting flowers near resource-rich areas, as spores are more likely to settle where they can quickly gather food or materials. This dual approach ensures that attracted spores not only arrive but also thrive upon settlement.
A cautionary note: over-reliance on spore flowers can lead to resource depletion if not managed carefully. Each flower consumes nutrients from the soil, so plant them judiciously and rotate their placement to prevent soil exhaustion. Additionally, be mindful of the colony’s carrying capacity; attracting too many spores without adequate infrastructure can lead to overcrowding and decreased efficiency. Balance is key—use spore flowers as a catalyst, not the sole driver of growth.
In practice, this strategy yields measurable results. Players who implement spore flower clusters near colonies often report a 30–50% increase in spore attraction rates within the first in-game month. For advanced players, combining this tactic with spore-attracting creatures or pheromone-emitting structures can further amplify growth. Whether you’re a novice or a seasoned player, mastering the art of spore flower placement is a game-changer for colony expansion.
Understanding Mold Spores: Formation, Growth, and Environmental Factors
You may want to see also

Upgrade Colony Plots: Use resources to upgrade colony plots, increasing their capacity for more spores
Upgrading colony plots is a strategic move in Spore that directly impacts your civilization's growth. Each plot upgrade increases the number of spores it can support, allowing for a larger, more robust colony. This process requires resources, which means you'll need to balance your gathering efforts with your expansion goals. For instance, a Level 1 plot might support 10 spores, but upgrading it to Level 2 could double that capacity. Understanding this mechanic is crucial for players aiming to dominate their planet.
To upgrade a colony plot, follow these steps: first, ensure you have sufficient resources, typically gathered through harvesting or trading. Next, select the plot you wish to upgrade and access the upgrade menu. The cost will vary depending on the level, with higher levels demanding more resources. For example, upgrading from Level 2 to Level 3 might require 50 food, 30 spice, and 20 gems. Plan your resource allocation carefully, as overextending can leave your colony vulnerable. Pro tip: prioritize upgrading plots near resource-rich areas to streamline future gathering.
While upgrading plots is effective, it’s not without risks. Over-reliance on a single resource type can make your colony susceptible to shortages if that resource becomes scarce. Additionally, upgrading too quickly can strain your economy, leaving fewer resources for defense or research. A balanced approach is key—upgrade plots incrementally, ensuring your resource production keeps pace with your expansion. For instance, if you’re low on spice, consider upgrading plots that primarily require food or gems instead.
Comparing plot upgrades to other expansion methods highlights their efficiency. Building new colonies from scratch requires significant time and resources, whereas upgrading existing plots maximizes your current infrastructure. However, new colonies offer the advantage of geographic diversification, reducing the risk of a single disaster wiping out your entire civilization. Players should weigh these factors based on their playstyle and current game state. For example, if you’re in a stable, resource-rich area, focus on upgrades; if you’re expanding into uncharted territory, consider founding new colonies.
In practice, upgrading colony plots is a long-term investment that pays dividends in population growth and resource management. By systematically increasing plot capacity, you create a sustainable foundation for your civilization’s advancement. Remember, the goal isn’t just to grow—it’s to grow smartly. Monitor your resource levels, plan upgrades strategically, and adapt to challenges as they arise. With patience and foresight, your colonies will thrive, setting the stage for interstellar exploration in the later stages of Spore.
Does Dead Mold Still Release Spores? Uncovering the Hidden Risks
You may want to see also

Complete Quests: Finish quests to unlock rewards that boost colony expansion and spore attraction
Quests in Spore are not just side activities; they are strategic opportunities to accelerate your colony's growth. Each quest completed unlocks rewards that directly or indirectly enhance your ability to expand and attract more spores. These rewards can range from resources and tools to special abilities and alliances, all of which are crucial for establishing thriving colonies. By prioritizing quests, you create a foundation for sustainable growth, ensuring your colonies are well-equipped to flourish in their environments.
To maximize the benefits of questing, focus on missions that align with your colony's immediate needs. For instance, resource-gathering quests can provide the raw materials necessary for constructing new buildings, while diplomatic quests might secure alliances that protect your colony from threats. Completing quests also increases your colony's reputation, making it more attractive to spores seeking stable and prosperous habitats. Keep an eye on the quest log and plan your actions to tackle the most rewarding tasks first, ensuring a steady stream of benefits.
One practical tip is to balance questing with other activities like exploration and combat. While quests offer significant rewards, neglecting other aspects of colony management can leave you vulnerable. For example, if you focus solely on quests, you might miss out on discovering rare resources or defending against unexpected attacks. Allocate time efficiently, perhaps dedicating specific in-game days to questing while ensuring your colony remains secure and productive.
Comparing quest rewards can also guide your decision-making. Some quests offer immediate benefits, like a boost in food or energy, while others provide long-term advantages, such as unlocking new technologies or increasing spore attraction rates. Evaluate your colony's current state and future goals to determine which rewards will have the most impact. For instance, if your colony is struggling with population growth, prioritize quests that enhance spore attraction or improve living conditions.
Finally, remember that quests often introduce you to new regions and species, expanding your understanding of the Spore universe. This knowledge can be invaluable for future expansion, as it helps you anticipate challenges and opportunities. By completing quests, you not only strengthen your current colonies but also lay the groundwork for establishing new ones in diverse and potentially more resource-rich environments. Treat each quest as a stepping stone toward becoming a dominant force in the galaxy.
Can You Spray Clorox on Mold Spores? A Complete Guide
You may want to see also
Explore related products

Strategic Placement: Place colonies near high-spore areas like gardens or spore-rich environments for faster growth
In the intricate world of spore cultivation, location is everything. Colonies thrive in environments teeming with their namesake, making strategic placement a cornerstone of successful propagation. Imagine a garden lush with decaying organic matter, where moisture clings to the air and sunlight filters through a canopy of leaves. This isn't just a picturesque scene—it's a spore paradise. By situating your colonies in such high-spore areas, you're not just placing them; you're immersing them in a nutrient-rich ecosystem primed for rapid growth.
Consider the mechanics of spore dispersal. In nature, spores travel on air currents, hitch rides on insects, or cling to water droplets. By placing colonies near gardens, compost piles, or damp basements, you're leveraging these natural pathways. For instance, a colony positioned near a mushroom-rich forest floor can absorb spores carried by foraging ants or wind gusts, exponentially increasing its exposure. This isn't guesswork—it's biology in action. Studies show that colonies in spore-dense zones can expand up to 50% faster than those in sterile environments.
However, strategic placement isn’t without its pitfalls. While spore-rich areas accelerate growth, they also introduce competition. Wild fungi and bacteria vie for the same resources, potentially overwhelming your colonies. To mitigate this, maintain a balance: choose locations with ample spores but minimal established growth. For example, a freshly turned compost pile offers abundant spores without the entrenched competitors found in an old, undisturbed patch. Additionally, monitor humidity levels; while spores love moisture, excessive dampness can invite mold or rot. Aim for a relative humidity of 60–70%—enough to keep spores airborne but not enough to drown your colonies.
For the home cultivator, practicality is key. If you lack access to outdoor gardens, recreate spore-rich conditions indoors. A terrarium with decaying leaves, moss, and a light misting system mimics a forest floor. Alternatively, place colonies near houseplants or aquariums, where spores naturally accumulate. Even a windowsill with a potted fern can serve as a micro-habitat. The goal is to think like a spore: where would you land? Follow that logic, and your colonies will flourish.
In essence, strategic placement is about harmony—aligning your colonies with the natural flow of spores. It’s not enough to simply introduce them to a spore-rich environment; you must understand and optimize that environment. By doing so, you’re not just growing colonies—you’re cultivating a self-sustaining ecosystem. Whether you’re a hobbyist or a professional, this approach transforms spore propagation from a gamble into a science. Place wisely, and watch your colonies thrive.
Where to Find and Legally Obtain Magic Mushroom Spores
You may want to see also

Use Spore Boosts: Activate spore boosts or power-ups to accelerate colony development and attract more spores
Spore boosts are your secret weapon for rapid colony expansion in *Spore*. These power-ups, scattered throughout the game, provide temporary enhancements that accelerate growth, increase spore attraction, and give your colony a competitive edge. Understanding how to find, activate, and maximize these boosts is crucial for players aiming to dominate their galactic neighborhood.
Spore boosts come in various forms, each targeting specific aspects of colony development. Some increase the rate at which your creatures reproduce, while others enhance their ability to gather resources or defend against predators. For instance, the "Fertility Boost" doubles your creatures' reproduction speed for a limited time, allowing your population to explode. Similarly, the "Resource Magnet" attracts nearby resources directly to your colony, streamlining your expansion efforts.
Activating spore boosts is straightforward but requires strategic timing. Most boosts are found in glowing orbs or chests hidden within the environment. Keep an eye out for shimmering objects or unusual terrain features, as these often indicate a boost’s location. Once discovered, simply interact with the object to activate the boost. However, be mindful of the boost’s duration—most last only a few minutes, so plan your actions accordingly. For example, activate a "Fertility Boost" when your colony has ample resources and is safe from threats to ensure maximum benefit.
While spore boosts are powerful, they are not a substitute for sound colony management. Over-reliance on boosts can lead to resource depletion or vulnerability if not paired with sustainable strategies. For instance, using a "Growth Spurt" boost without sufficient food reserves can result in starvation once the boost wears off. Pair boosts with long-term planning, such as establishing multiple resource-gathering sites or fortifying defenses. Additionally, prioritize boosts that align with your colony’s current needs—a "Defense Shield" might be more valuable during a predator invasion than a "Fertility Boost."
To maximize the impact of spore boosts, combine them with other in-game mechanics. For example, use the "Speed Boost" to quickly explore new areas and claim resources before competitors arrive. Pair the "Attraction Boost" with well-designed creature traits to lure more spores to your colony, accelerating evolution. Experiment with different boost combinations to discover synergies that suit your playstyle. Remember, the key to success lies in balancing boosts with strategic decision-making, ensuring your colony thrives both during and after their effects.
Spore Stains: Unlocking Microbial Identification and Diagnostic Precision
You may want to see also
Frequently asked questions
You unlock more colony slots by progressing through the Space Stage and increasing your empire's size and influence. Completing missions, allying with or conquering other empires, and expanding your territory will allow you to build more colonies.
To establish a new colony, you need Energy (collected from stars) and Spice (obtained through trade or conquest). Ensure you have enough of these resources before attempting to colonize a planet.
Not all planets can be colonized. Only planets with a habitable environment (indicated by a green icon) can support colonies. You can terraform planets to make them habitable if they are not initially suitable.
Colony population grows automatically over time, but you can speed up the process by placing additional colony pods on the planet. Each pod increases the population cap, allowing your colony to grow faster.

























